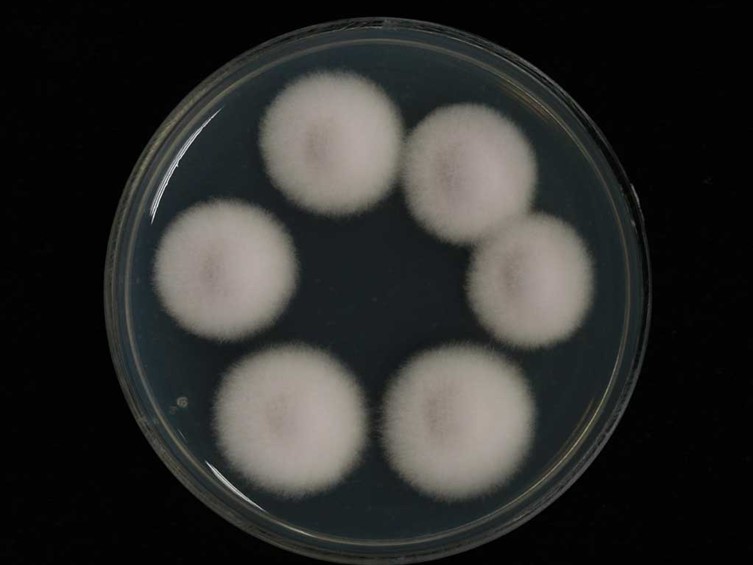

Holotype:
THAILAND, Nakhon Nayok Province, Khao Yai National Park, 14 Apr. 1997, N.L. Hywel-Jones, holotype NHJ 00885, extype living culture BCC 1376.
Habitat:
Buried in the ground.
Host:
Lepidoptera larva.
Description:
 Stroma solitary, white to whitish-purple, becoming purple around ostioles, 40-55 mm long, 3-4 mm wide.
Stroma solitary, white to whitish-purple, becoming purple around ostioles, 40-55 mm long, 3-4 mm wide.  Perithecia pseudoimmersed to almost superficial with scattered wefts of mycelia or pseudoparenchymatous cells surrounding the perithecium, oblique, ovoid, hyaline wall, 330-420 × 200-270 µm. Asci hyaline, cylindric, capitate, 8-spored, 200-350 × 5-6 µm.
Perithecia pseudoimmersed to almost superficial with scattered wefts of mycelia or pseudoparenchymatous cells surrounding the perithecium, oblique, ovoid, hyaline wall, 330-420 × 200-270 µm. Asci hyaline, cylindric, capitate, 8-spored, 200-350 × 5-6 µm.  Ascospores smooth, filiform, hyaline, multi-septate, non-fragmenting, 160-250 × 1 µm.
Ascospores smooth, filiform, hyaline, multi-septate, non-fragmenting, 160-250 × 1 µm.
Culture characteristics:
Colonies on PDA attaining a diam of 15–17 mm in 7 d, white to creamy, cottony, dense mycelium, reverse tawny olive. Hyphae septate, smooth-walled, hyaline, 1–2 μm diam. Phialides lecanicillium-like, arising from aerial hyphae, cylindrical, tapering gradually towards the apex, hyaline, solitary or more often 2 or 4 in whorls on each node, 3–18 × 1–2 μm. Conidia in long chains, hyaline, ovoid, 2–3.5 × 1–2 μm.
Colonies on PDA attaining a diam of 15–17 mm in 7 d, white to creamy, cottony, dense mycelium, reverse tawny olive. Hyphae septate, smooth-walled, hyaline, 1–2 μm diam. Phialides lecanicillium-like, arising from aerial hyphae, cylindrical, tapering gradually towards the apex, hyaline, solitary or more often 2 or 4 in whorls on each node, 3–18 × 1–2 μm. Conidia in long chains, hyaline, ovoid, 2–3.5 × 1–2 μm.
Reference:
Hywel-Jones NL (1994). Cordyceps khaoyaiensis and C. pseudomilitaris, two new pathogens of lepidopteran larvae from Thailand, Mycological Research 98 : 939–942.
DOI: https://doi.org/10.1016/S0953-7562(09)80267-0Mongkolsamrit S, Khonsanit A, Thanakitpipattana D, et al. (2020). Revisiting Metarhizium and the description of new species from Thailand. Studies in Mycology 95: 171–251.
DOI: https://doi.org/10.3114/fuse.2021.08.03Species |
Strain |
Compound |
Pubchem CID |
Biological activity |
Reference |
|---|
|
Strain |
LSU | RPB2 | SSU | TEF1 |
|---|---|---|---|---|
| BCC 1376 | KX983462 | KX983465 | KX983468 | KX983457 |
| BCC 14290 | KX983463 | KX983466 | KX983469 | KX983458 |
| BCC 44287 | KX983464 | KX983467 | KX983470 | KX983459 |